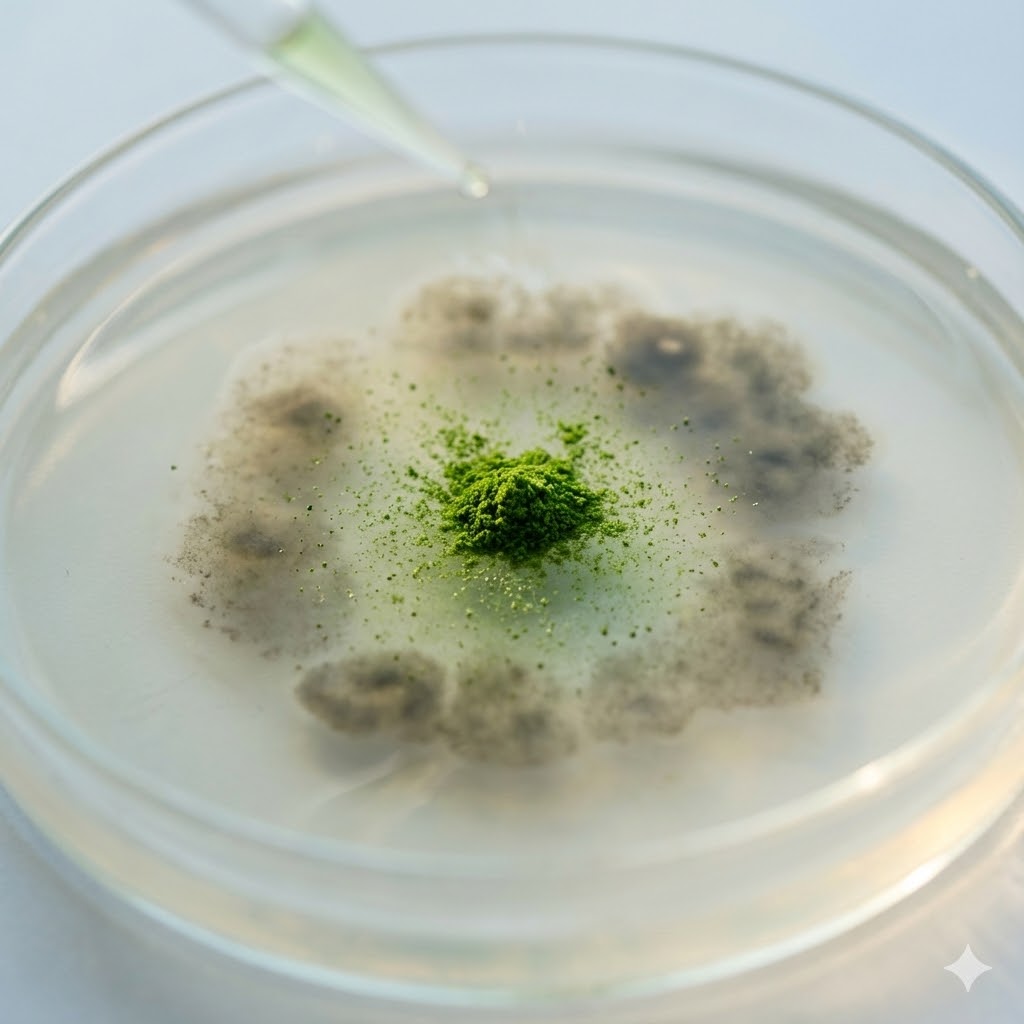
Byggræs symboliseret ved en petriskål med grå enheder i en cirkel. i midten en grøn enhed.

Byggræs og kræft
Resumé om byggræs
Virkning:
- Byggræs er spækket med vitaminer og naturlige plantestoffer, der renser ud i kroppen og giver immunforsvaret et solidt løft, så det bedre kan modstå stress og sygdom.
Potentiale ved kræft:
- Forskning viser, at byggræs kan være med til at bremse kræftcellers vækst og hjælpe kroppen med at slå dem ihjel, samtidig med at det dæmper den betændelse i vævet, som kræften ofte udnytter.
Vigtigste begrænsning:
- De gode resultater stammer fortrinsvis fra laboratorie- og dyreforsøg. Derfor ved vi endnu ikke med sikkerhed, præcis hvor meget der skal til, for at det virker som egentlig behandling på mennesker.
Hvad er byggræs

Byggræs er de spæde, grønne skud af bygplanten (Hordeum vulgare), som høstes meget tidligt i vækstfasen – længe før planten danner korn. På dette stadie er planten ernæringsmæssigt unik og minder mere om en koncentreret grøntsag end en kornsort. De unge blade er fyldt med klorofyl, vitaminer, mineraler og enzymer, som planten skal bruge til sin eksplosive vækst.
For at bevare de sarte, aktive stoffer bliver græsset typisk presset til saft og frysetørret eller tørret ved lave temperaturer straks efter høst. Dette sikrer et højt indhold af bioaktive komponenter, som ellers ville gå tabt ved opvarmning eller lagring.
Historie
Selvom byg har været dyrket som fødevare i tusinder af år, er det først i nyere tid, at videnskaben har rettet blikket mod de unge græsskud.
Den japanske forsker Dr. Yoshihide Hagiwara var pioner på området i 1960’erne, men det er inden for de seneste år, at man med moderne teknologi har kunnet kortlægge præcis, hvordan de enkelte molekyler i græsset påvirker vores celler på gen-niveau.
Virkningsmekanismer

Byggræssets effekt skyldes en kompleks synergi mellem flere bioaktive stoffer. Det handler ikke kun om vitaminer, men om specifikke plantemolekyler, der kan “tale” til vores celler.
Regulering af Wnt-signalvejen
En af de mest interessante nye opdagelser er byggræssets evne til at påvirke den såkaldte Wnt/β-catenin signalvej. Dette er en kommunikationslinje inde i cellerne, som ofte er overaktiv ved kræft, hvilket får cellerne til at dele sig uhæmmet. Nye studier viser, at fenoler i byggræs kan dæmpe denne signalvej, hvilket bremser den ukontrollerede cellevækst [1].
Modulering af immunsystemet
Byggræs indeholder specifikke polysakkarider (komplekse kulhydrater), der fungerer som immun-modulatorer. De stimulerer kroppens Natural Killer (NK) celler, som er immunforsvarets forreste linje i kampen mod unormale celler. Ved at gøre disse celler mere aggressive over for trusler, styrkes kroppens eget forsvar [3].
ROS og apoptose
En klassisk mekanisme, der er bekræftet i flere studier, er evnen til at øge niveauet af reaktive iltforbindelser (ROS) specifikt inde i kræftcellerne.
Mens raske celler kan neutralisere disse, bliver kræftcellerne overbelastet af oxidativt stress og tvinges til at begå apoptose (programmeret celledød) [5].
Potentiale ved kræft

Forskningen tegner et billede af et potentiale, der spænder over flere kræftformer, idet byggræs angriber sygdommen fra forskellige vinkler.
Tarmkræft og gen-regulering
Den nyeste forskning (2025) fokuserer på tarmkræft. Her har man set, at ekstrakter af byggræs effektivt kan mindske tumorudvikling ved direkte at hæmme de gener (Wnt-pathway), der driver kræften.
Samtidig forbedres tarmbarrieren, hvilket forhindrer giftstoffer i at sive ud i kroppen og skabe inflammation [1].
Bryst- og prostatakræft
Tidligere nøglestudier har vist, at byggræs er i stand til at standse væksten i cellelinjer fra både bryst- og prostatakræft.
Ved at aktivere enzymer (caspaser), der fungerer som cellens “selvmords-knap”, induceres celledød i de syge celler uden at skade det omkringliggende raske væv [5].
Leukæmi og lymfom
Ved blodkræfttyper som leukæmi og lymfom har man observeret, at stoffer i grøn byg kan gribe ind i kræftcellernes livscyklus. Byggræsset bremser cellerne i deres delingsfase (G2/M-fasen), så de ikke kan formere sig, hvilket effektivt stopper sygdommens spredning i laboratoriemodeller [6].
Angiogenese og metastasering
Der er også tegn på, at stoffer i byggræs (bl.a. saponiner) kan hæmme angiogenese – dannelsen af nye blodkar til tumoren. Uden blodforsyning kan en tumor ikke vokse eller sprede sig. Studier indikerer, at disse stoffer kan regulere kolesterol-metabolismen i kræftcellerne, hvilket gør det sværere for dem at overleve [2].
Fordele ved byggræs

Udover de specifikke anti-cancer mekanismer, tilbyder byggræs en række fordele, der støtter den generelle sundhedstilstand.
Genopbygning af tarmmiljøet
For mange patienter er fordøjelsen belastet af medicin og stress. Byggræs indeholder fibre og næringsstoffer, der aktivt hjælper med at genoprette en sund tarmflora, hvilket er afgørende for både immunforsvar og optagelse af næring.
Letoptagelig næring
Da det indtages flydende (opblandet pulver), kræver det minimal fordøjelsesenergi. Det giver en hurtig tilførsel af mikronæringsstoffer til en krop, der måske er træt og har nedsat appetit, uden at man skal spise store mængder mad.
Ulemper og begrænsninger

Selvom potentialet er stort, er der praktiske forhold, man skal være opmærksom på.
Smagen kræver tilvænning
Byggræs har en meget markant smag af “grønt”, som kan være svær for nogle at acceptere, især hvis man oplever kvalme. Det kan dog ofte maskeres i smoothies med citron eller ingefær.
Behov for klinisk validering
Selvom de molekylære mekanismer nu er godt kortlagt i laboratoriet og i dyremodeller, mangler der stadig de helt store forsøg, hvor man giver byggræs til mennesker i kræftbehandling og måler effekten over tid. Det meste viden er derfor stadig “præklinisk”. Hvor der skal komme midler fra til en sådan forskning er vanskelig at se, da medicinalindustrien næppe ønsker at finansiere dette.
Kliniske studier

Forskningen i byggræs kombinerer i dag ny viden om genterapi og immunregulering med tidligere fund om direkte celledrab. Referencerne i links-sektionen dækker denne bredde fra molekylærbiologi til dyreforsøg. [1-6]
Sikkerhed
Byggræs er et fødevareprodukt og har en høj sikkerhedsprofil.
K-vitamin og blodfortyndende medicin
Vær opmærksom på det høje indhold af K-vitamin. Hvis du tager blodfortyndende medicin (f.eks. Marevan), kan et stort indtag af grønt nedsætte medicinens virkning. Tal altid med din behandler om dette.
Glutenfri status
Selve græsset indeholder ikke gluten, men risikoen for “smitte” fra korn under høst eller produktion er reel. Vælg altid produkter, der er certificeret glutenfri, hvis du har intolerans overfor gluten.
Dispensering og anvendelse

For at bevare de aktive stoffer bedst muligt, anbefales følgende fremgangsmåde:
Produktvalg
- Pulver af græssaft: Ofte den bedste kvalitet, da fibrene er sorteret fra, hvilket giver en højere koncentration af aktive stoffer.
- Frysetørret: Sikrer at enzymer og varmefølsomme vitaminer er intakte.
Indtagelse
- Kold anvendelse: Bland altid i kold væske. Varme ødelægger enzymerne øjeblikkeligt!
- På tom mave: Mange oplever bedst effekt ved at drikke det om morgenen, ca. 20 minutter før mad, for optimal optagelse.
- Dosis: Start med 1 tsk. og trap langsomt op til 1-2 spsk. dagligt.
Forskel på byggræs, chlorella og spirulina

Selvom de alle tre omtales som “superfoods” og har en dybgrøn farve, er der væsentlige forskelle på deres biologiske profil og primære virkning i kroppen. Det kan være relevant at kende forskel, hvis man søger en specifik effekt.
Byggræs
Styrken ved byggræs ligger i det høje indhold af levende enzymer, herunder den kraftige antioxidant SOD (Superoxid Dismutase). Da det er presset af ungt græs, har det en meget bredspektret vitaminprofil og virker stærkt basedannende. Det anses ofte som det “mildeste” valg for maven og smager mindre kraftigt end de to alger. Det er særligt velegnet til cellebeskyttelse og enzym-støtte.
Chlorella
Denne ferskvandsalge er kongen af klorofyl. Den indeholder mere klorofyl pr. gram end nogen anden plante, hvilket gør den til den mest effektive “renser”.
Chlorella er unik på grund af sin evne til at binde tungmetaller og giftstoffer i tarmen, hvilket gør den populær til afgiftning. Den har en hård cellevæg, som skal være “knust” (broken cell wall) for at mennesket kan optage næringen.
Spirulina
Spirulina er en blågrøn alge (cyanobakterie), der adskiller sig ved at indeholde det sjældne blå pigment phycocyanin, som har vist stærke immunregulerende egenskaber. Den har et meget højt proteinindhold (ca. 60-70%) og indeholder ingen cellulose, hvilket gør den ekstremt let at fordøje for svækkede personer.
Den vælges ofte for energi og styrkelse af immunforsvaret.
Strategisk placering og kombination

For at forstå byggræssets rolle i en samlet behandlingsplan, inddeles det typisk efter dets primære funktion i kroppen.
Type: Repair
Byggræs hører primært til i Repair-kategorien (genopbygning). Dets hovedopgave er at styrke “terrænet” – altså at gøre kroppen stærk, basisk og modstandsdygtig, så immunforsvaret kan fungere. På grund af de nyere fund omkring apoptose og Wnt-signalveje, har det dog også sekundære Kill-egenskaber, hvilket gør det til et mere aktivt tilskud end almindelige vitaminpiller.
Synergi
Byggræs fungerer sjældent bedst alene. Det indgår ofte i “holdopstillinger” med andre stoffer for at øge effekten:
- C-vitamin: At tilsætte citronsaft eller tage C-vitamin sammen med byggræs øger optagelsen af plantens jern og antioxidanter markant.
- Chlorella og Spirulina: Disse tre “grønne” supplerer hinanden. Hvor byggræs leverer enzymerne, leverer chlorella bindemidlet til affaldsstoffer, og spirulina leverer proteinerne. De kan med fordel blandes.
- Sunde fedtstoffer: Da byggræs indeholder K- og E-vitamin (fedtopløselige), kan en smule olie (f.eks. hørfrøolie eller omega-3) hjælpe med optagelsen.
Vigtigt – Antagonister
- Varme: Den absolut største fjende. Bland aldrig i varm te eller kaffe.
- Oxiderende behandlinger: Hvis man får behandlinger, der virker ved at skabe frie radikaler (visse typer kemo/ stråling), anbefaler nogle behandlere at holde pause med stærke antioxidanter som byggræs på selve behandlingsdagene for ikke at modvirke behandlingen. Dette bør altid afklares med behandleren.
Konklusion

Byggræs har i lyset af den samlede forskning bevæget sig fra at være et simpelt vitamintilskud til at være en potent bioaktiv fødevare.
Evnen til at påvirke fundamentale processer som Wnt-signalvejen, inflammation og apoptose på tværs af flere kræftformer gør det til et yderst relevant supplement.
Selvom det ikke kan stå alene som behandling, understøtter det kroppen på flere vitale fronter samtidig [1, 3, 5].
Vær opmærksom på, at det ikke må indtages i forbindelse med kemoterapi-typer eller strålebehandling, der udnytter oxidativ stress.
Tilbage til Kosttilskud
Se også Anthony William (den medicinske seer)
Se også Bill Henderson Protokol (Budwig & Rath)
Se også Medicin logistik
Links
[1] Phenolic Extracts of Hulless Barley Grass Alleviate Progression of Colitis-Related Colorectal Cancer by Inhibiting the Overexpression of Wnt/β-Catenin Signaling Pathway (PubMed, 2025)
- Indhold: Et helt nyt in vivo studie, der påviser, hvordan ekstrakter af byggræs effektivt hæmmer tumorudvikling ved tarmkræft ved at blokere specifikke signalveje og dæmpe inflammation.
- Indhold: En omfattende gennemgang af, hvordan stoffet saponarin (fundet i byggræs) bekæmper kræft ved at stoppe dannelsen af nye blodkar til tumoren og dæmpe inflammation.
[3] Immunomodulatory Properties of Polysaccharide-Rich Young Green Barley Extract (MDPI, Molecules, 2022)
- Indhold: Dette studie dokumenterer, hvordan kulhydrater fra ungt byggræs stimulerer immunforsvaret, især NK-cellerne, til bedre at genkende og eliminere kræftceller.
[4] Barley Grains and Barley Grass – Nutritional Value and Therapeutic Potential (Hop and Medical Plants, Hamei, 2023)
- Indhold: En nyere videnskabelig opdatering på byggræssets potentiale, der sammenholder de ernæringsmæssige fordele med den nyeste viden om sygdomsforebyggelse og kræft.
[5] Barley grass extract causes apoptosis of cancer cells by increasing intracellular reactive oxygen species production (Biomedical Reports, 2017)
- Indhold: Et vigtigt grundstudie der påviser, at ekstrakt af byggræs dræber bryst- og prostatakræftceller ved at øge mængden af reaktive iltforbindelser i cellerne.
[6] Searching in Mother Nature for Anti-Cancer Activity: Anti-Proliferative and Pro-Apoptotic Effect Elicited by Green Barley on Leukemia/Lymphoma Cells (PLoS One, 2013)
- Indhold: Undersøgelse der viser, at grøn bygekstrakt selektivt hæmmer væksten af leukæmi- og lymfomceller ved at standse deres cellecyklus.
Siden er oprettet:
d. 03.01.26
❤
Hvad du læser på Jeg har Kræft er ikke en anbefaling. Søg kompetent vejledning.

